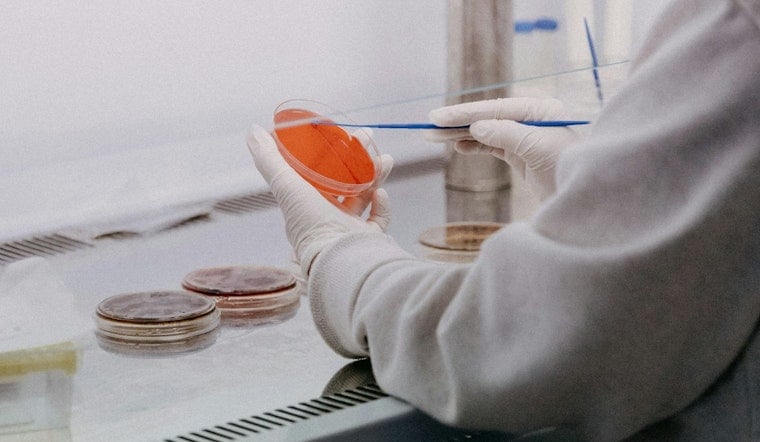
North Chicago's Helix 51 Gears Up For Big Biotech Growth Spurt

Rosalind Franklin University's Helix 51 biomedical incubator in North Chicago is on track to double its footprint, a move university and county leaders say will bring more wet-lab benches and space for additional early-stage biotech firms. The planned expansion is meant to give startups closer, more affordable access to lab infrastructure and a clearer route from campus research to commercial operations. For Lake County boosters, the buildout is a wager that extra lab capacity will keep life-science jobs rooted in the suburbs instead of nudging founders into downtown Chicago.
As reported by Crain's Chicago Business, RFU filed plans this month to expand Helix 51 and nearly double the incubator's footprint. The outlet notes that the move is intended to create more slots for lab-based startups and strengthen connections between university researchers and nearby biopharma employers.
What Helix 51 Looks Like Now
Rosalind Franklin University opened Helix 51 inside its Innovation and Research Park as a combined wet-and-dry lab incubator and has described the space as roughly 6,500 square feet with a class-100,000 clean room, shared core equipment, and support programs for entrepreneurs, according to a press release via PR Newswire. "The growth of our Helix 51 incubator over the last five years brings to the RFU campus a range of novel therapeutic and diagnostic alternatives that will hopefully benefit patients around the globe," RFU research leader Dr. Ronald Kaplan said in that release. The facility was set up as a soft landing for early-stage and international life-science companies seeking a foothold in the Chicago-area biotech ecosystem.
Who’s Moving In And The Local Pipeline
Lake County economic-development officials say the incubator has pulled in startups including AirAnswers, Everyplace Labs and ARTEC Biotech, and that the planned buildout would create room for roughly nine more lab-based firms, per Lake County Partners. That local pipeline is one reason companies outside downtown Chicago have been willing to base themselves at RFU's Innovation and Research Park: it offers bench space, university collaboration and proximity to established manufacturers and corporate R&D centers. For founders, those perks can translate into faster technical milestones and lower early-stage costs.
Incubator Wins And Ongoing Research
The incubator is already producing grant-winning work: a Helix 51 tenant, UP Oncolytics, was awarded an Illinois Innovation Voucher for $75,000 to collaborate with RFU researchers, according to a PR Newswire notice in January 2026. Other teams have moved in more recently, such as Monopar Therapeutics, which announced it joined Helix 51 in early 2025, coverage of which appeared on BioSpace, underscoring that the park attracts both early-stage and clinical-stage enterprises.
Why Lake County Is Betting On Biotech
Economic-development groups and industry advocates frame the expansion as part of a broader push to build out a Lake County bioscience corridor that can feed talent to nearby pharmaceutical and device firms, as outlined by iBIO. The RFU campus sits roughly between Chicago and Milwaukee and keeps startups a short drive from major employers and contract manufacturers while offering lower real-estate costs than downtown lab districts. Officials say more wet-lab capacity will help retain talent, boost local hiring and make the suburb a more tempting spot for investors and founders alike.
Crain's Chicago Business notes the university has moved the plan into filings this month and that RFU and county officials are pitching the buildout as a pragmatic way to accelerate spinouts and hiring. If the expansion proceeds on the timeline organizers are hoping for, it could add both specialized lab jobs and the service-sector roles that support a growing life-science cluster around RFU's campus.









